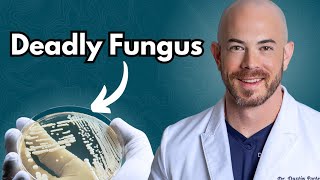

Candida Auris: Is this deadly fungus a cause for concern? video
Online izle ve mp4 mp3 formatlarinda yukle

Videonun muddeti: 1:58
Candida Auris: Is this deadly fungus a cause for concern? videosu mp4 ve mp3 yuklemek ucun hazirdir
Diqqet! Siz Mp4 yukle ve ya Mp3 yukle duymesine basdiqdan sonra eger sistem sizi reklam sehifesine atarsa o zaman derhal geri qayidib emeliyyati tekrar edin ve faylin yuklemek ucun hazir olmasini gozleyin
Videodan Mp4 Yukle
Videodan Mp3 Yukle-1
Videodan Mp3 Yukle-2
Oxshar Axtarishlar
 Candida Auris: Is this deadly fungus a cause for concern?
Candida Auris: Is this deadly fungus a cause for concern? What is Candida Auris? (Deadly Fungus?)
What is Candida Auris? (Deadly Fungus?) CDC says dangerous fungus Candida auris spreading; Cleveland Clinic specialist provides guidance
CDC says dangerous fungus Candida auris spreading; Cleveland Clinic specialist provides guidance Doctors voice concerns over deadly fungal infection
Doctors voice concerns over deadly fungal infection CDC issues warning about a fungus called Candida auris
CDC issues warning about a fungus called Candida auris CDC: Deadly fungal infection Candida auris spreading at alarming rate | FOX 5 DC
CDC: Deadly fungal infection Candida auris spreading at alarming rate | FOX 5 DC Growing concern over rise of fungal infections in healthcare facilities
Growing concern over rise of fungal infections in healthcare facilities What is Deadly Fungal Infection | Treatment of Candida Auris:
What is Deadly Fungal Infection | Treatment of Candida Auris: Deadly fungus that can cause serious and sometimes fatal infections in human is an emerging threat
Deadly fungus that can cause serious and sometimes fatal infections in human is an emerging threat
Video Mp4 Mp3Azwap.Biz
Azwap.Biz 2021-2023


 Candida Auris: Is this deadly fungus a cause for concern?
Candida Auris: Is this deadly fungus a cause for concern? What is Candida Auris? (Deadly Fungus?)
What is Candida Auris? (Deadly Fungus?) CDC says dangerous fungus Candida auris spreading; Cleveland Clinic specialist provides guidance
CDC says dangerous fungus Candida auris spreading; Cleveland Clinic specialist provides guidance Doctors voice concerns over deadly fungal infection
Doctors voice concerns over deadly fungal infection CDC issues warning about a fungus called Candida auris
CDC issues warning about a fungus called Candida auris CDC: Deadly fungal infection Candida auris spreading at alarming rate | FOX 5 DC
CDC: Deadly fungal infection Candida auris spreading at alarming rate | FOX 5 DC Growing concern over rise of fungal infections in healthcare facilities
Growing concern over rise of fungal infections in healthcare facilities What is Deadly Fungal Infection | Treatment of Candida Auris:
What is Deadly Fungal Infection | Treatment of Candida Auris: Deadly fungus that can cause serious and sometimes fatal infections in human is an emerging threat
Deadly fungus that can cause serious and sometimes fatal infections in human is an emerging threat